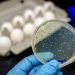
काभ्रे जिल्लाको ५० प्रतिशत खानेपानीको स्रोतमा भेटियो ‘फेइकल कोलिफर्म–इकोली’

ब्रसेल्स । युरोपेली संघ काउन्सिलले ईयु विदेश मन्त्रीहरूले युक्रेनलाई हतियार आपूर्तिका लागि पैसा छुट्याएको उल्लेख गरेको रुसी समाचार एजेन्सी तासले जनाएको छ ।
लक्जेम्बर्गमा भएको बैठकपछि ईयुका २७ सदस्य राष्ट्रका विदेश मन्त्रीहरूले युरोपेली शान्ति सुविधामा ३।५ बिलियन युरोको बजेट बढाएर अनुमोदन गरेका छन् । साथै ब्रसेल्सले युक्रेनलाई हतियार आपूर्तिको लागि रकम विनियोजन गरेको छ ।
सोमबारको विज्ञप्तिमा भनिएको छ -काउन्सिलले आज युरोपेली शान्ति सुविधाको समग्र वित्तीय सीमा सन् २०२३ मार्च २० बाट लागू हुने गरी अघिल्लो सम्झौताको आधारमा सो थप रकम वृद्धि गर्ने निर्णय गरेको छ ।
“यो कार्य वित्तीय दिगोपन र सुरक्षित र शान्तिपूर्ण भविष्य सुनिश्चित गर्न र यसको विश्वव्यापी भौगोलिक दायरा र सङ्कट र द्वन्द्वहरूलाई रोक्न र त्यसका लागि शीघ्र प्रतिक्रिया गर्ने ईयुको क्षमतालाई जोगाउनको लागि हो,” विज्ञप्तिमा भनिएको छ ।